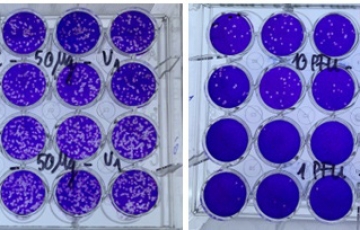
Việt Nam thử nghiệm thuốc điều trị COVID-19 trên người

ĐỒNG HỒ CHÍNH HÃNG NHẬP TỪ NHÀ MÁY
 Địa chỉ: Lô C, c/c 189BC - Quỳnh, P. Nguyễn Cư Trinh, Q.1, TP. HCM
Địa chỉ: Lô C, c/c 189BC - Quỳnh, P. Nguyễn Cư Trinh, Q.1, TP. HCM
Vaccine COVID-19 Covivac có mức liều 3mcg và 6mcg cho thử nghiệm trên người giai đoạn 2
Hôm nay, 11/8, bắt đầu khám sàng lọc, chọn người tình nguyện tiêm thử nghiệm mũi 1 vaccine COVID-19 Covivac giai đoạn 2 của Việt Nam. Ở giai đoạn này, có nhiều thay...
Việt Nam thử nghiệm thuốc điều trị COVID-19 trên người
Kết quả nghiên cứu tiền lâm sàng thuốc trị COVID-19 Vipdervir đã chứng minh tính an toàn và khả năng ức chế phát triển SARS-CoV-2 cũng như tăng cường miễn dị...

HƯỚNG DẪN PHÂN BIỆT ĐỒNG HỒ CHÍNH HÃNG VÀ ĐỒNG HỒ NGA FAKE MẪU QUỐC HUY VIỆT NAM
Quốc Huy là biểu tượng không chỉ của Việt Nam màm đối với mỗi người dân Việt Nam. Do đó, mẫu Quốc Huy được sản xuất trên các biểu tượng, các sản phẩm...

Bàn giao tàu tìm kiếm cứu nạn tàu ngầm: Bước tiến lớn...
- Xây dựng ý tưởng, thiết kế sáng tạo riêng mới là khâu quan trọng giúp chúng ta có được những con tàu của chính mình...

DN Việt chế tạo giàn khoan cho mỏ dầu "khủng" thế giới
- Công ty Dịch vụ Cơ khí Hàng hải PTSC (PTSC M&C) trúng thầu chế tạo giàn khoan cho một trong những mỏ dầu ngoài khơi lớn nhất thế giới.

CHỨNG NHẬN HỔ PHÁCH NGA CỦA RUSSIANWATCHES
Hổ phách là loại đá đặc biệt được đánh giá cao trong các dòng trang sức.

